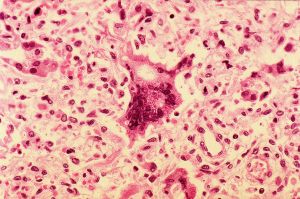
The measles virus

News
Port of Port Angeles faces loss of $222,660 in annual lease income when Westport cabinetry shop moves to former Walmart building
PORT ANGELES — The Port of Port Angeles must plug a $222,660 hole in annual income — plus…